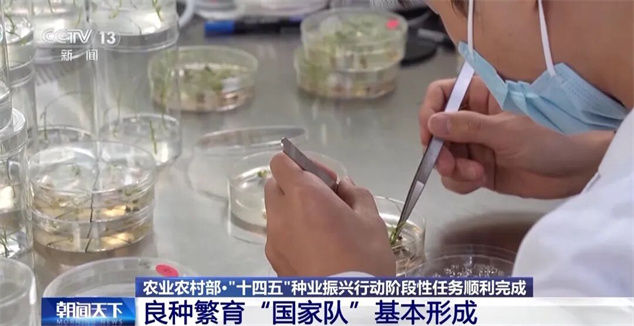

農(nóng)業(yè)現(xiàn)代化,種子是基礎(chǔ)。據(jù)農(nóng)業(yè)農(nóng)村部,“十四五”時(shí)期,我國啟動(dòng)種業(yè)振興行動(dòng),目前,階段性任務(wù)順利完成。
“十四五”時(shí)期,農(nóng)業(yè)種質(zhì)資源“家底”更加厚實(shí)。我國完成新中國成立以來規(guī)模最大、覆蓋范圍最廣的全國農(nóng)業(yè)種質(zhì)資源普查,摸清了資源家底,并建成國際一流的農(nóng)作物、畜禽、海洋漁業(yè)三大國家種質(zhì)庫,資源保存總量躍居世界第一。

“十四五”時(shí)期,種業(yè)科技創(chuàng)新整體進(jìn)入世界第一方陣。培育出高抗赤霉病小麥、抗稻飛虱水稻、耐密宜機(jī)收玉米、耐除草劑高油高產(chǎn)大豆等一批重大新品種。
“十四五”時(shí)期,種業(yè)基地供種能力明顯增強(qiáng)。以甘肅玉米、四川水稻、黑龍江大豆、海南南繁四大國家級(jí)育制種基地為核心的良種繁育“國家隊(duì)”基本形成。目前,國家級(jí)種業(yè)基地供種保障率達(dá)到80%,比2020年提高10個(gè)百分點(diǎn)。

種業(yè)振興行動(dòng)啟動(dòng)五年來,目前我國種源安全水平穩(wěn)步提升,農(nóng)作物自主選育品種占比95%以上,畜禽、水產(chǎn)國產(chǎn)種源市場(chǎng)占有率分別超過80%和85%。農(nóng)業(yè)用種安全總體有保障、風(fēng)險(xiǎn)可管控的態(tài)勢(shì)更加牢固。












